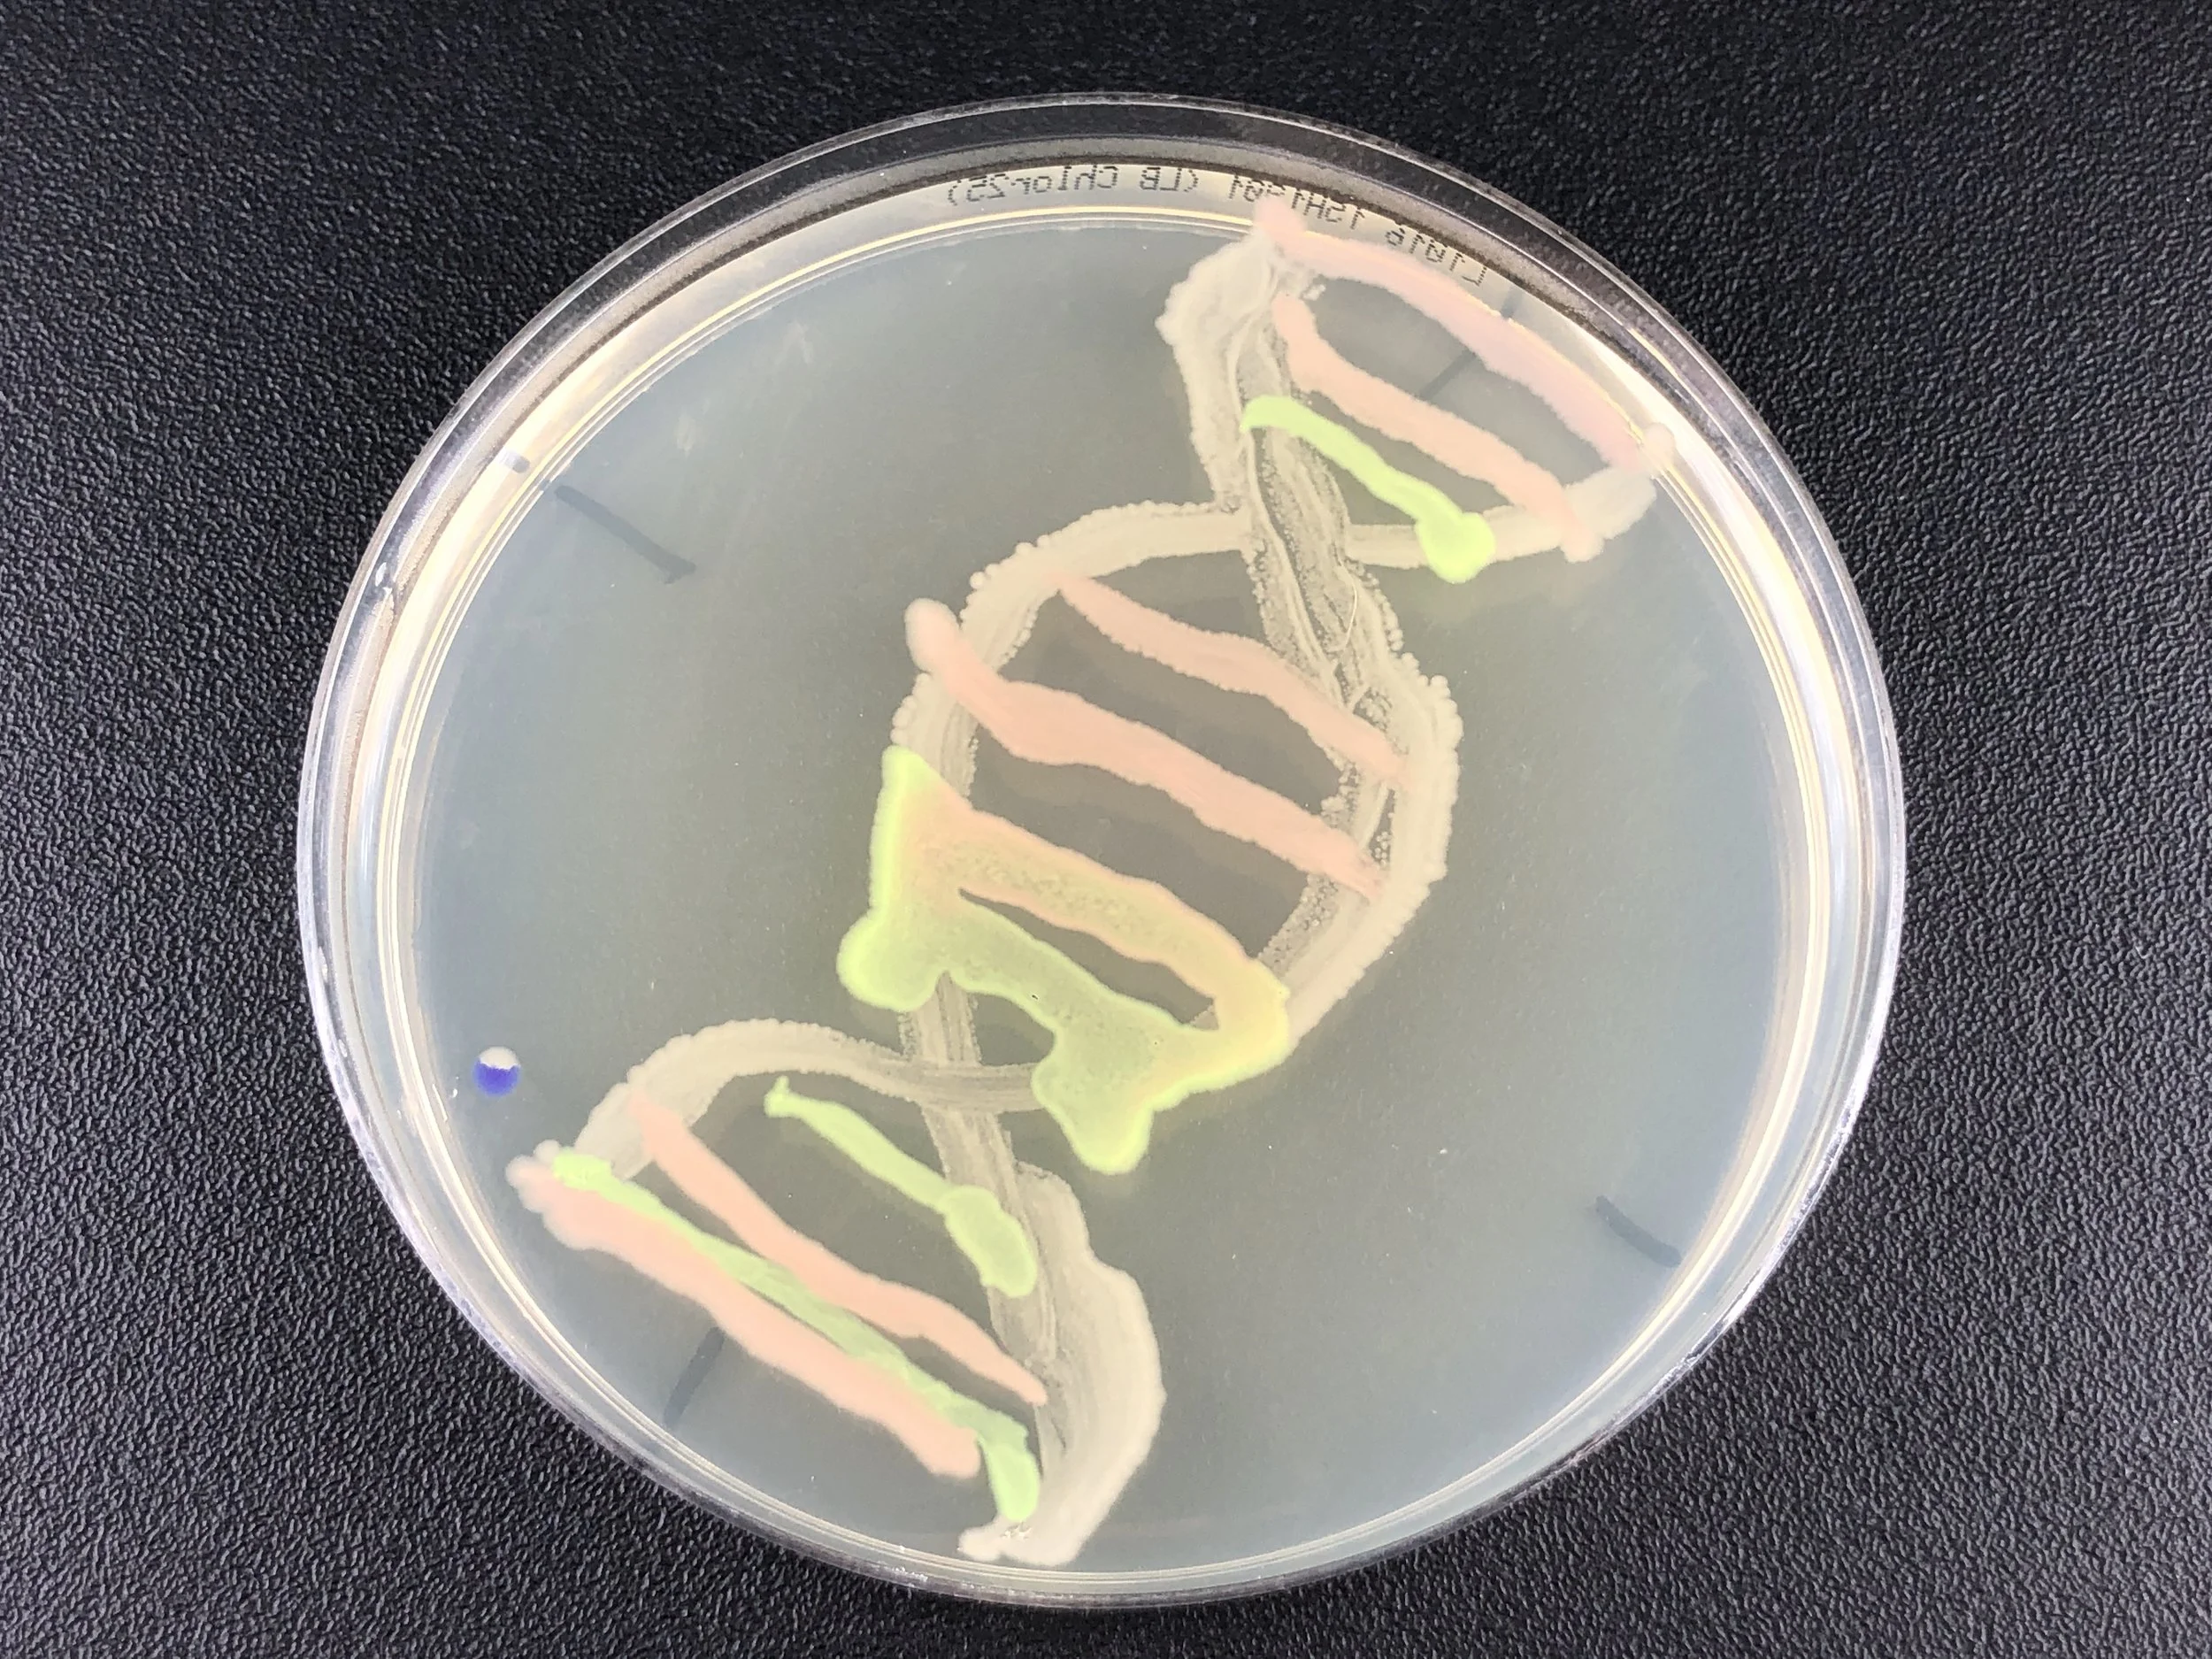

Talks, Panels, & Breakout Sessions
Throughout the weekend, Bio Summit will be live on Zoom!
Find a full list of events, organized by date. Or, sort by subject or type by clicking the links below.
To find each events’ Zoom links, please click on the event you’d like to attend.
Events are being added every day, and the full schedule will be coming soon!
Click below to see each day’s events in a Google Doc
Friday, Jan. 27 | Saturday, Jan. 28 | Sunday, Jan. 29
Click below to see events by subject track
- Ancient Future Technology 2
- BioArt & Design 14
- Building Diverse & Inclusive Communities 7
- Closing Session 2
- Communicating Science 1
- Diversity & Inclusion 1
- Environmental Stewardship 1
- Governance 16
- Learning & Education 7
- Open Innovation 6
- Plenary 17
- Regional Meetings 1
- Responding to Global Health Challenges 1
- Workshop 18
- Youth in Science 1
Click below to see events by type
- Ancient Future Technology
- Bio Art & Design
- Bio Creation Station
- Building Collaborations
- Building Diverse & Inclusive Communities
- Diversity & Inclusion
- Environmental Stewardship
- Global Health Challenges
- Governance
- Learning & Education
- Open Innovation
- Opening
- Plenary
- Regional Meetings
- Sharing Resources
- Workshop
- Workshops
- Youth in Science
Click below to enter Zoom Rooms
Throughout the weekend, all events will be held in parallel zoom rooms. We refer to these rooms by the names of organelles in a cell! You can click on the organelles below to enter their corresponding Zoom room, or copy the link into your browser.
Note: All times are shown in Eastern Time.
To find your time zone, use this handy time zone converter!


Work in progress - a network support system
by Roudlotul Jannah, Science Communication Steering Group - iGEM Community
Abstract: It is a peer support network for people doing science. A safe space where anyone can turn to when they need someone to talk. Believing that sharing of stories has the power to influence and inspire will not only encourage conversation about the necessity of mental health and balance in research but also will serve as a way to bring people closer together by sharing universal human experiences.

Working with the Open Yeast Collection
by Scott Pownall, Open Science Network Society, USA
Abstract: In this webinar you will learn what the Open Yeast Collection is and how to work with it to accomplish your goals. You will learn what the collection provides and what you have to bring to the table to create solutions to your goals. Many of the concepts in this webinar also apply to working with the Open Bioeconomy Lab’s Open Enzyme Collection, Open Reporters and E. coli Protein Expression Kit, also included in the 2022 iGEM Distribution. This webinar is suitable for all participants interested in innovation using synthetic biology.

Exploring the future of biodesign through interactive play
by Jimena Segura
Abstract: This workshop is aimed at young people, STEM educators who want to know and explore how they can implement the game with educational kits to explore the future of biodesign with biomaterials. Providing interactive dynamics and understanding the real dimension and impact if we introduce young generations to these topics.

Design a Collaboration Stack for Global Self-Governance
by Day Waterbury, Consensual Ventures, USA
Abstract: In this participatory workshop/exploration we will begin from first principles and emerge with a rough outline for a Collaboration Stack for Global Self-Governance. We will identify certain features and functions it must have, and others which it must not have. We start with the goal of global healing and regeneration: Assuming a set of values or desired outcomes, we have to make sense of where we are and what dynamics are in play in order to make an actionable plan that will move us in the direction of those outcomes. This is a fundamental prerequisite of getting oriented before setting out on a journey. We take the lay of the land and find our north star and, as David Ehrlichman points out in Impact Networks, we "plan for emergence". We will absolutely run into unanticipated challenges and opportunities along the way, so this isn't about an exhaustive mapping exercise. The important thing is to begin, and the first step in beginning, is sensemaking. It isn't really linear because this is also an ongoing activity that is a part of every subsequent step along the way. We can feel the ground under our feet and we make adjustments as necessary, a little this way or that for mud or gravel or a root we just noticed. This is about being agile and ready to respond.

Regional Meetings
North America Regional, hosted by Tim Dobbs, Jessica McGrath, & Patrik D’haeseleer
Zoom Room: NUCLEUS: https://mit.zoom.us/j/99832288319
Latin America Regional, hosted by Beno Juarez, Eduardo Padhilla, Heloisa Oss Boll, Heidi Jalkh
Zoom Room: RIBOSOME: https://mit.zoom.us/j/99732148040
Europe Regional, hosted by Jan-Maarten, Arunav Konwar, Kenza, Vittorio Milone
Zoom Room: LYSOSOME: https://mit.zoom.us/j/97427389199
Africa Regional, hosted by Oluwadamilaola Ogunjobi, Hatem, Prince Edem Samoh
Zoom Room: GOLGI: https://mit.zoom.us/j/97316973390

Tour around the Bio Creation Station with Scientists
with Rosario Flores Vallejo and Maritza Alonso
Introduction/Moderator: Kalaumari Mayoral Peña
Abstract: Talk about bioart and biodesign works with scientists. They will guide participants through their favorite works from the Bio Creation Station. During the visit, all questions and reflections from participants will be welcomed. Join us!

Mentorship in the Round, Youths’ Growing Role in Biodesign Education
by Corinne Takara
Introduction to Youth in Science by Jess
Introduction to Workshops by Saleem
Introduction to Regionals by Maria

Amazon Floating Fab: Towards a Regenerative Design
by Beno Juarez (Amazon Floating Fab)
Elaine to introduce Ancient Future Technology

Ecological Kinship: Indigenous Knowledge and Planetary Relations
by
Dr. Maria Kicking Horse Lawrence, Rhode Island College, USA
Dr. Kathleen Nolan, Guelph University, Canada
Keshia De Freece, Sovereign Science, USA
Briar Gugler, Sovereign Science, USA
Janey Hecht (Moderator) Bard College, USA
Akira Iyashikei, Indigenous Media Collective, USA


Building global collaborations for access to reagents
by Jenny Molloy (Open BioEconomy Lab, Cambridge, UK)


Closing Session
Reflections from the Day
Biocreation Station Showcase!
Open Mic! Hosted by Maria Chavez (BioCurious) and Friends
99BIO SUMMIT PARTY!!!! Featuring DJ Philip Tan, DJ Kongo, & DJ Nora Saurus!!!
![Panel III: [Bio Spaces as Learning Environments]](https://images.squarespace-cdn.com/content/v1/5f201c898b5f5516ea2b6ec0/1674866141594-4HVGDBQEFRY615A630QB/Captura+de+tela+2023-01-27+213532.png)
Panel III: [Bio Spaces as Learning Environments]
Moderator: Don Pinkerton
(5 minutes) Overview
(7 minutes) Corinne Takara, Okada Design
(7 minutes) Wendy Pouliot, BosLab
(7 minutes) Lisa Schiefele, BUGGS
(7 minutes) Beth Tuck, Genspace
(12 minutes) Q&A Session with the Panelists
(5 Minutes) Closing Remarks from the Panelists

Digital infrastructure for operating an autonomous shared lab space guided by member consensus
Digital infrastructure for operating an autonomous shared lab space guided by member consensus by Danny Chan
Abstract: The exact circumstances that will constrain a community lab are unique to the founders’ resources (eg, social, fiscal, material) as well as the members of the lab at any given moment. In a community lab with the value of autonomy (possibly coded as self-sustaining, independent, etc), members will need a space where conflicts can be resolved openly. Furthermore, a mechanism to identify how shared resources are used create an opportunity for more advanced collaboration. Transparency regarding the shared resources helps to hold gatekeepers accountable for the implementation of consensus. This is the model of an autonomous lab that is exemplified by Biotech Without Borders (BwoB), a community based in NYC. In this workshop participants will make a decision via consensus through 2 key software platforms that are used at Biotech Without Borders. Participants must create accounts on these software spaces and will participate within the BwoB structure. The first software is Loomio, a decision making software developed for and by cooperative businesses that enables users to discuss and ultimately vote on proposals asynchronously. The second is Open Collective, a financial tool that allows contributions to be collected in transparent budgets and dispensed as appropriate.
INSTRUCTIONS: https://drive.google.com/file/d/1Ss69cpvR_cvYPg1xNXLAMAUKdaFeRryf/view?usp=sharing

Science and Automation
(20 minutes) Nath Arushi - Dragonfly Bot: Learning from Nature using Neurons and Logic Gates
(20 minutes) David Castillo - Proteopresso: Affordable, automated chromatography at a glance.
(20 minutes) Dahlin Zevallos - Development of a mercury whole cell biosensor
(20 minutes) Mehreen Raza - Promoting open source science & technology
(30 minutes) Tim Dobbs - Open Auto Club: Open-Source Robots For Al
![Panel II: [Instructional Innovation with Tools & Technologies]](https://images.squarespace-cdn.com/content/v1/5f201c898b5f5516ea2b6ec0/1674866045465-ZYNTAUFRU7RQI65CRZTU/Captura+de+tela+2023-01-27+213352.png)
Panel II: [Instructional Innovation with Tools & Technologies]
Moderator: Kenza Samlali
(5 minutes) Overview
(10 minutes) Alisha Collins (Brilliant Labs, Canada)
(10 minutes) Isabel Correa (Teachers College, Costa Rica)
(15 minutes) Q&A Session with the Panelists
(5 Minutes) Closing Remarks from the Panelists

Thinking Without a Brain: Biomaking Exploration with Slime Mold
Thinking Without a Brain: Biomaking Exploration with Slime Mold by Alisha Collins (Director of Creative Learning, Brilliant Labs), Nirosha Murugan (Algoma University) and Will Collins (Director of Bio-Innovation, Brilliant Labs)
Abstract: Let's investigate ways to engage brainless organisms, such as a slime mold to make decisions and solve mazes. Physarum polycephalum-slime mold can effectively find the shortest route through a maze. What if we could collaborate with them for problem-solving and devising better-networked systems?

Learning & Education Track LIGHTNING TALK II
5 Minute Introduction
LIGHTNING TALK II
5 Minute Closing/Run over

Automation, Data, and Medical Innovation
(20 minutes) Blair Subbaraman - Custom Workflow Automation Using Jubilee: Duckweed Growth Assays
(20 minutes) Peter Collins - Biotorrents.de update
(10 minutes) Ryutaro Nishimura - Effect of placenta (placental preparation) on cell proliferation
(30 minutes) Jia-En Chen - Open Source Medical Supplies in Taiwan and Metal 3D Printing Techniques Assist Pelvic Surgery
![Panel I: [Innovation in Curriculum and Instruction]](https://images.squarespace-cdn.com/content/v1/5f201c898b5f5516ea2b6ec0/1674865854731-0HFDC63KGCLX0NNJ2CLS/Captura+de+tela+2023-01-27+213040.png)
Panel I: [Innovation in Curriculum and Instruction]
Moderator: Bushra - E - Anjum
(5 minutes) Overview
(7 minutes) Anja Scholze (The Tech Interactive, US)
(7 minutes) Georg Tremmel (BioClub Tokyo, Japan)
(7 minutes) Cynthia-Elizabeth Valenzuela-Chapa (Sebiotec Space Tec de Mty, Mexico)
(7 minutes) Espinoza-Cara Rosario (Universidad Nacional de Rosario, Argentina)
(12 minutes) Q&A Session with the Panelists
(5 Minutes) Closing Remarks from the Panelists

Yeastograms
Yeastograms by Guenter Seyfried, pavillon_35, Austria
Abstract: Yeastograms are living pictures carved with UV light into yeast cultures in petri dishes. In the workshop, participants learned how to grow these organisms into shapes using stencils the participants made on their computers. In a follow up online event the group discussed the results and analyzed the parameters accordingly; for example, how to adjust the yeast concentration to the size of the halftone pattern of the stencil and other fine details. In the reflection it was also possible to consider new applications using the principles of the Yeastogram method on mycelium, scoby and many more things. Günter Seyfried and Lucas Czjzek developed the Yeastogram method, which was used for components of Czjzek’s artwork Anima, trying out many setups to tease out the envisioned aesthetic quality. The recipe was published in 2013 and introduced as a “new” form of handcraft in artistic and scientific communities and ultimately to a wider public.

Open Innovation Track Science Sessions
(20 minutes) Daniel Geurra - Plasmid reporters for biofilm differentiation in Pseudomonas
(20 minutes) Rachel Aronoff - Open Science to Solve Problems
(30 minutes) Scott Pownall - A sequel to the Open Yeast Collection
(20 minutes) Felipe Navarro - ReClone and open access to biological reagents

Learning & Education Track Introduction
5 Minute Introduction
LIGHTNING TALK I
5 Minute Closing/Run over


Knitting Water
Knitting Water by Laura Rodriguez, Bioartist, Mexico/Netherlands
Abstract: Can we encapsulate stories? Can we catch the water with our hands?
These are sculptures that represent specific times, tales and conditions of the vital element of water. Each participant will create strings of alginate encapsulating the water sample they collected and create a story or reason behind the object according to the collected data or the subjective importance of this water sample for the subject. We will knit with bio-strings made of alginate, as a bioplastic.
MATERIALS NEEDED: https://drive.google.com/drive/folders/19-No-YYE6ZoyMmTQw-klffYh5d9vpBdY?usp=sharing